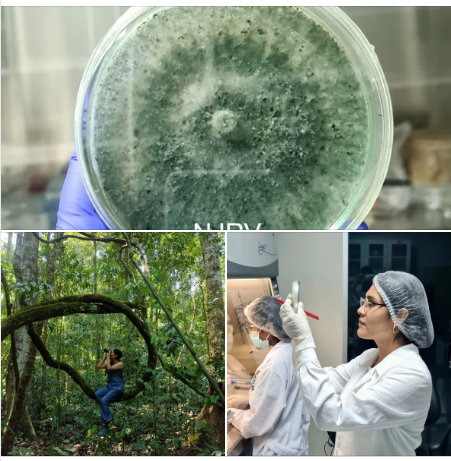

#EGRESADOS |![]()
![]()
![]()
EGRESADOS DE LA FACULTAD DE CIENCIAS BIOLÓGICAS DE LA UNIVERSIDAD NACIONAL SAN LUIS GONZAGA PUBLICAN HALLAZGO CIENTÍFICO EN REVISTA INTERNACIONAL
La Universidad Nacional San Luis Gonzaga celebra el logro de nuestros egresados M.Sc. Blga. Naysha Rojas-Villa y Ph.D. (c) Phillip Ormeño-Vásquez, quienes lideran una publicación en la revista Agriculture (MDPI, Q1, IF = 3.6 indexada en Scopus y Web of Science) que reporta por primera vez dos especies del hongo benéfico Trichoderma para el Perú.
El estudio, desarrollado en suelos de la selva central peruana (Chanchamayo), identificó las especies T. azadirachtae y T. anisohamatum, previamente conocidas solo en Asia y con capacidad de colonizar a la planta. Lo más destacado: las cepas nativas aisladas tuvieron un desempeño in vitro igual o superior al producto comercial en su capacidad para combatir a Botrytis cinerea, hongo que causa pérdidas millonarias en cultivos de fresa, uva y arándano.
Esta investigación es fruto de una sólida colaboración entre instituciones de Perú, Chile y Argentina. El trabajo fue desarrollado en el Centro Internacional de Investigación para la Sustentabilidad (UNDC) y contó con la participación de un equipo multidisciplinario: Ph.D. Paula Pedrozo (CONICET, Argentina), Ph.D. (c) Betza Oré-Asto, Jherimy Moriano-Camposano (estudiante)y el Ph.D. Luis A. Álvarez, quien formó parte de nuestra casa de estudios y actualmente es Docente Investigador en la Universidad Nacional de Cañete.
Este trabajo demuestra el potencial de la biodiversidad microbiana peruana para desarrollar alternativas sostenibles en agricultura y reafirma que el talento San luisano trasciende fronteras, integrándose con éxito a redes científicas internacionales.
Agriculture 2026, 16, 112
https://doi.org/10.3390/agriculture16010112